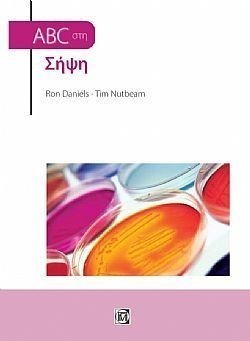
S��S� CU� ��

ΚΑΤΗΓΟΡΙΕΣ
NEWSLETTER
Συπληρώστε το email σας
για να λάβετε τις προσφορές
και τα νέα της Bookstation
ΝΕΟΙ ΤΙΤΛΟΙ
-
Νέος Κώδικας για Δημόσιες Συμβάσεις -11η έκδοση
Κωτσοβίνος Ευαγ. Βασίλης προσθήκη στο καλάθι
προσθήκη στο καλάθι
ISBN 978-618-84598-2-3
Τιμή | 54 € -
Πλήρης Οδηγός Φορολογιών Κατοχής Ακινήτων (Δήλωση Ε9/ΕΝΦΙΑ-Πιστοποιητικό/ΕΦΑ)
Αννα Κόλλια προσθήκη στο καλάθι
προσθήκη στο καλάθι
ISBN 978-618-83144-9-8
Τιμή | 54 € -
Οι κωδικοί του Ε9 (Δήλωση Ακινήτων)-2024 -ΑΜΕΣΑ ΔΙΑΘΕΣΙΜΟ
Ορέστης Εμμ. Σεϊμένης-Μανούσος Ιωάν. Ντουκάκης προσθήκη στο καλάθι
προσθήκη στο καλάθι
ISBN 978-618-87035-0-6
Τιμή | 54 €
περισσότερα >
Κατηγορίες / . / Ιατρική & υγεία / Ανθρωπολογία / Γενικοί Τίτλοι / ABC Στη Σήψη
ABC Στη Σήψη
Ron Daniels, Tim Nutbeam
Εκδόσεις
Παρισιάνου Α.Ε.
ISBN: 978-960-583-390-9
Κωδικός: 77115073
Σελίδες: 98
Σχήμα: 21Χ29 cm
Εξώφυλλο: Χαρτόδετο
Ημερομηνία έκδοσης: 2018
Τιμή | 0 €
ΑΝΑΖΗΤΗΣΗ
Σε όλες τις κατηγορίες
ΑΝΑΚΟΙΝΩΣΕΙΣ
9/5/2012 2:16:56 μμ
περισσότερα >
BEST SELLERS
-
Νέος Κώδικας για Δημόσιες Συμβάσεις -11η έκδοση
Κωτσοβίνος Ευαγ. Βασίλης προσθήκη στο καλάθι
προσθήκη στο καλάθι
ISBN 978-618-84598-2-3
Τιμή | 54 € -
Λατινικά ...για 20! (για τη Γ' Λυκείου)
Χρήστος Ζηκούλης προσθήκη στο καλάθι
προσθήκη στο καλάθι
ISBN 978-618-5837-00-6
Τιμή | 50 € -
Λατινικά...για 20! (Για τη Β' λυκείου)
Χρήστος Ζηκούλης προσθήκη στο καλάθι
προσθήκη στο καλάθι
ISBN 978-618-86835-9-4
Τιμή | 25 €
περισσότερα >


